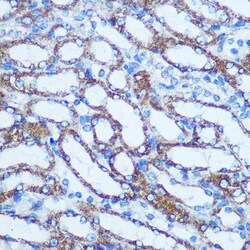
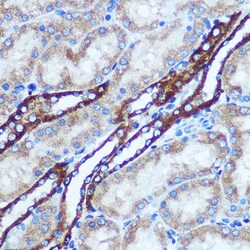

Learn More
Invitrogen™ GSTT1 Polyclonal Antibody


Rabbit Polyclonal Antibody
Supplier: Invitrogen™ PA588823
Description
Positive Samples: HepG2, Mouse liver, Mouse kidney; Cellular Location: Cytoplasm Immunogen sequence: MGLELYLDLL SQPCRAVYIF AKKNDIPFEL RIVDLIKGQH LSDAFAQVNP LKKVPALKDG DFTLTESVAI LLYLTRKYKV PDYWYPQDLQ ARARVDEYLA WQHTTLRRSC LRALWHKVMF PVFLGEPVSP QTLAATLAEL DVTLQLLEDK FLQNKAFLTG PHISLADLVA ITELMHPVGA GCQVFEGRPK LATWRQRVEA AVGEDLFQEA HEVILKAKDF PPADPTIKQK LMPWVLAMIR.
Glutathione S-transferase (GST) theta 1 (GSTT1) is a member of a superfamily of proteins that catalyze the conjugation of reduced glutathione to a variety of electrophilic and hydrophobic compounds. Human GSTs can be divided into five main classes: alpha, mu, pi, theta, and zeta. The theta class includes GSTT1 and GSTT2. The GSTT1 and GSTT2 share 55% amino acid sequence identity and both of them were claimed to have an important role in human carcinogenesis. The GSTT1 gene is located approximately 50kb away from the GSTT2 gene. The GSTT1 and GSTT2 genes have a similar structure, being composed of five exons with identical exon/intron boundaries.
Specifications
| GSTT1 | |
| Polyclonal | |
| Unconjugated | |
| Gstt1 | |
| AI255817; Glutathione S-transferase 1 (theta); glutathione S-transferase 5; glutathione S-transferase theta 1; glutathione S-transferase theta-1; glutathione S-transferase, theta 1; glutathione transferase T1-1; GST 5-5; GST class-theta-1; GSTT1; Gstt1-1; GSTYRS; similar to Glutathione S-transferase theta 1 (GST class-theta 1) (Glutathione transferase T1-1) | |
| Rabbit | |
| Affinity Chromatography | |
| RUO | |
| 14871, 25260, 2952 | |
| -20°C, Avoid Freeze/Thaw Cycles | |
| Liquid |
| ELISA, Immunohistochemistry (Paraffin), Western Blot, Immunocytochemistry | |
| 0.59 mg/mL | |
| PBS with 50% glycerol and 0.09% sodium azide; pH 7.3 | |
| P30711, Q01579, Q64471 | |
| Gstt1 | |
| Recombinant fusion protein containing a sequence corresponding to amino acids 1-240 of GSTT1 (NP_0008442). | |
| 100 μL | |
| Primary | |
| Human, Mouse, Rat | |
| Antibody | |
| IgG |
Your input is important to us. Please complete this form to provide feedback related to the content on this product.